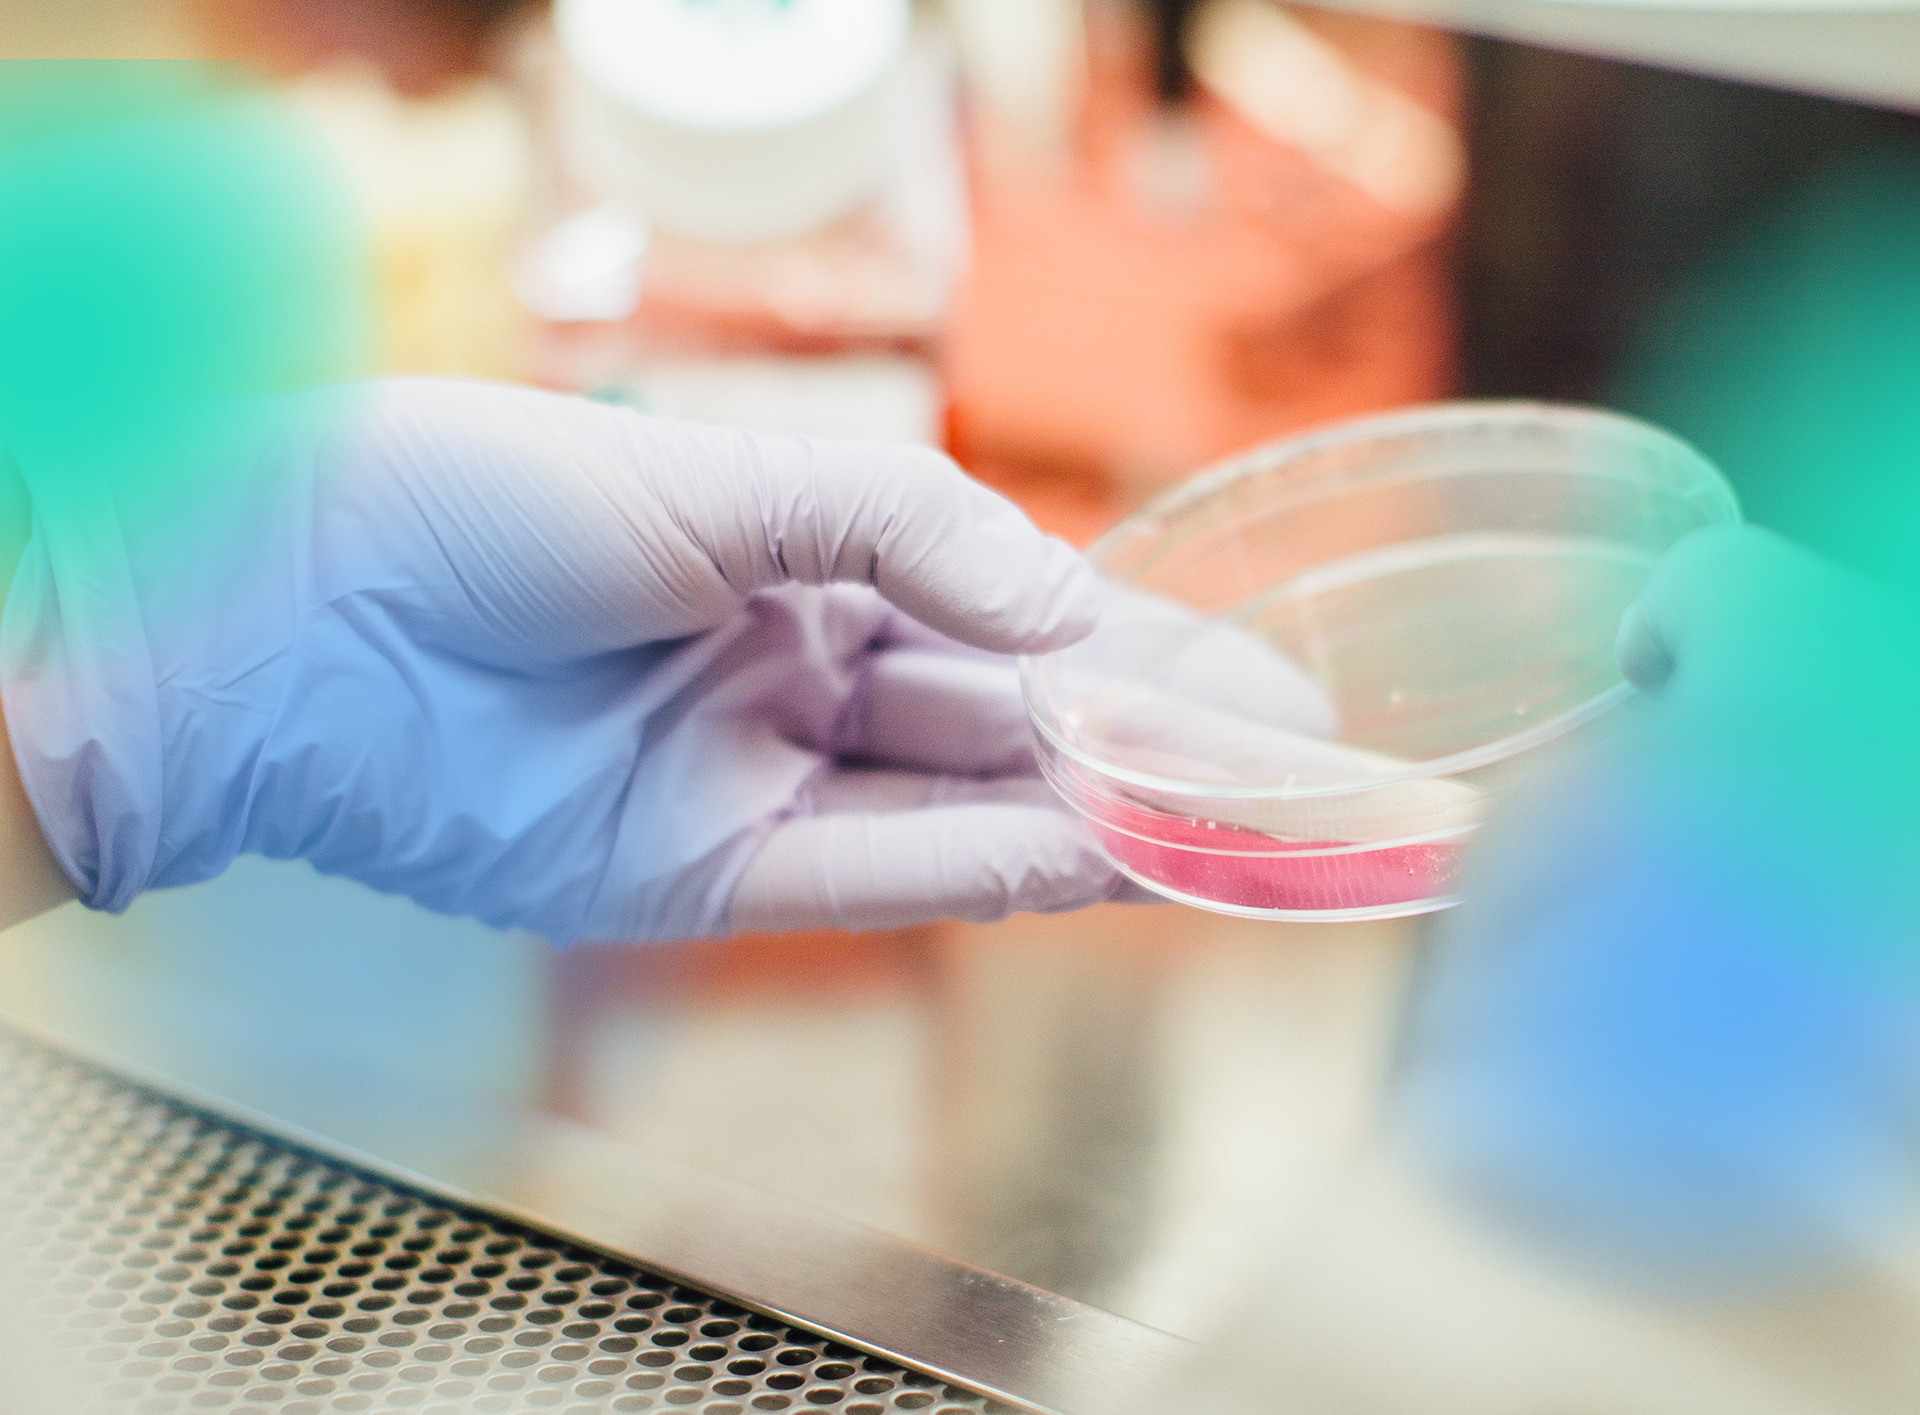
header-1_20230317154014608

Wegwerpkleding
Wegwerpkleding draagt men over de huidige kleding en kunt u na gebruik weggooien. Het is belangrijk dat beschermende wegwerpkleding allereerst comfortabel draagt en niet te strak zit zodat men voldoende bewegingsvrijheid heeft. Dat wil zeggen dat de drager er zich goed in kan bewegen, zonder er hinder van te ondervinden.
Poetspapier
Bij H&D trading vindt u een uitgebreid assortiment poetspapier.
De papierrollen poetsrollen in het assortiment van H&D trading zijn beschikbaar in verschillende formaten, kleuren en kwaliteiten. Uiteraard hebben we voor elke rol een passende dispenser of vloer- of muurstandaard beschikbaar. De kwaliteit van een poetspapier is van groot belang.
Werkhandschoenen
Werkhandschoenen zijn misschien wel de belangrijkste gereedschappen van u en uw medewerkers. Het uitgebreide assortiment werkhandschoenen van H&D Trading biedt bescherming bij alle typen werkzaamheden en elke omstandigheid. Zo verkleint u de kans op handletsel. Een goede handbescherming is daarom net zo belangrijk als de handen zelf.
Disposables
Bij H&D Trading vindt u een compleet assortiment disposables, beschermende kleding, werkhandschoenen, adembescherming,
gehoorbescherming, handdoeken, reinigingsmiddelen, zeep, poetsdoeken en EHBO-artikelen. Schoon werken begint bij de juiste beschermende kleding. Bij H&D Trading vindt u daarom het meest complete assortiment disposables.
gehoorbescherming, handdoeken, reinigingsmiddelen, zeep, poetsdoeken en EHBO-artikelen. Schoon werken begint bij de juiste beschermende kleding. Bij H&D Trading vindt u daarom het meest complete assortiment disposables.
_20260312115744957.jpg)











